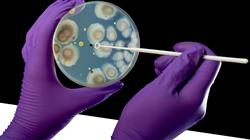
##IMAGE##

Qualificação universitária
Com esta Capacitação Prática, você dará um grande passo em sua carreira.”
Porquê estudar no TECH?
Através desse programa, você aprenderá a utilizar os novos procedimentos para a detecção e o tratamento de doenças como a febre amarela ou a malária”

Nos países em desenvolvimento, a transmissão de doenças tropicais é muito comum porque eles têm poucos recursos econômicos e de saúde para combater sua disseminação. Nesse sentido, milhares de viajantes chegam aos consultórios médicos ou hospitais com diferentes patologias desse tipo. Como resultado, surgiram recentemente novos mecanismos de prevenção, detecção e tratamento dessas doenças para evitá-las, e, em caso de contágio, garantir uma ótima recuperação. Por esse motivo, os profissionais especializados nessa área da medicina são obrigados a dominar todos esses avanços para oferecer um serviço de saúde de qualidade e preservar a saúde do paciente intacta. Considerando esse cenário e com o objetivo de de proporcionar aos médicos essas novas habilidades, a TECH elaborou este programa exclusivamente prático.
Durante 3 semanas intensivas, o médico aproveitará um estágio prático em um centro hospitalar conceituado, com a tecnologia e as ferramentas mais modernas à sua disposição. Como parte de uma equipe multidisciplinar composta pelos melhores profissionais da medicina, o aluno observará e realizará os procedimentos mais atualizados no âmbito das doenças tropicais. Dessa forma, o profissional realizará os tratamentos mais eficientes para combater patologias bacterianas e fúngicas ou atualizará suas habilidades em métodos de prevenção e detecção.
Para garantir a excelência desse período acadêmico, os alunos serão acompanhados durante todo o estágio no hospital por um orientador especialmente designado, que será responsável por solucionar todas as suas dúvidas e assegurar a aprendizagem adequada. A Capacitação Prática representa, portanto, uma oportunidade excelente para atuar na linha de frente da área médica em um período muito curto e junto com os maiores especialistas.
Desfrute de uma estadia intensiva de três semanas em um centro de prestígio e atualize-se nos mais recentes procedimentos clínicos para crescer profissionalmente”
Porquê estudar no TECH?
A TECH é a maior universidade digital do mundo. Com um impressionante catálogo de mais de 14.000 programas universitários, disponíveis em 11 línguas, posiciona-se como líder em empregabilidade, com uma taxa de colocação profissional de 99%. Além disso, possui um enorme corpo docente de mais de 6.000 professores de renome internacional.
Estuda na maior universidade digital do mundo e garante o teu sucesso profissional. O futuro começa na TECH”
A melhor universidade online do mundo segundo a FORBES
A prestigiada revista Forbes, especializada em negócios e finanças, destacou a TECH como «a melhor universidade online do mundo». Foi o que afirmaram recentemente num artigo da sua edição digital, no qual fazem eco da história de sucesso desta instituição, «graças à oferta académica que proporciona, à seleção do seu corpo docente e a um método de aprendizagem inovador destinado a formar os profissionais do futuro».
Um método de estudo inovador, um corpo docente de vanguarda e a sua orientação prática: a chave do sucesso da TECH.
Os planos de estudos mais completos do panorama universitário
A TECH oferece os planos de estudos mais completos do panorama universitário, com programas que abrangem os conceitos fundamentais e, ao mesmo tempo, os principais avanços científicos nas suas áreas científicas específicas. Além disso, estes programas são continuamente atualizados para garantir aos estudantes a vanguarda académica e as competências profissionais mais procuradas. Desta forma, os cursos da universidade proporcionam aos seus alunos uma vantagem significativa para impulsionar as suas carreiras com sucesso.
A TECH possui os planos de estudos mais completos e intensivos do panorama universitário atual.
O melhor corpo docente top internacional
O corpo docente da TECH é composto por mais de 6.000 professores de renome internacional. Professores, investigadores e quadros superiores de multinacionais, incluindo Isaiah Covington, treinador de desempenho dos Boston Celtics; Magda Romanska, investigadora principal do Harvard MetaLAB; Ignacio Wistumba, presidente do departamento de patologia molecular translacional do MD Anderson Cancer Center; e D.W. Pine, diretor criativo da revista TIME, entre outros.
Especialistas de renome internacional, especializados em vários ramos da Saúde, Tecnologia, Comunicação e Negócios, fazem parte do corpo docente da TECH.
Um método de aprendizagem único
Um método de aprendizagem único A ##UNIVERS IDAD_SIGLAS## é a primeira universidade a utilizar o Relearning em todos os seus cursos. É a melhor metodologia de aprendizagem online, acreditada com certificações internacionais de qualidade de ensino, fornecidas por agências educacionais de prestígio. Além disso, este modelo académico disruptivo é complementado pelo “Método do Caso”, configurando assim uma estratégia única de ensino online. São também implementados recursos didácticos inovadores, incluindo vídeos detalhados, infografias e resumos interativos.
A TECH combina o Relearning e o Método do Caso em todos os seus programas universitários para garantir uma excelente aprendizagem teórica e prática, estudando quando e onde quiser.
A maior universidade digital do mundo
A TECH é a maior universidade digital do mundo. Somos a maior instituição educativa, com o melhor e mais extenso catálogo educativo digital, cem por cento online abrangendo a grande maioria das áreas do conhecimento. Oferecemos o maior número de títulos próprios, pós-graduações e licenciaturas oficiais do mundo. No total, são mais de 14.000 títulos universitários, em onze línguas diferentes, o que nos torna a maior instituição de ensino do mundo.
A TECH conta com o mais extenso catálogo de programas académicos e oficiais do mundo e está disponível em mais de 11 línguas.
Google Partner Premier
O gigante tecnológico americano atribuiu à TECH o distintivo Google Partner Premier. Este prémio, que só está disponível para 3% das empresas no mundo, destaca a experiência eficaz, flexível e adaptada que esta universidade proporciona aos estudantes. O reconhecimento não só acredita o máximo rigor, desempenho e investimento nas infra-estruturas digitais da TECH, mas também coloca esta universidade como uma das empresas de tecnologia mais avançadas do mundo.
A Google colocou a TECH no top 3% das empresas tecnológicas mais importantes do mundo, atribuindo-lhe o distintivo Google Partner Premier.
A universidade online oficial da NBA
A TECH é a Universidade Online Oficial da NBA. Através de um acordo com a maior liga de basquetebol, oferece aos seus estudantes programas universitários exclusivos, bem como uma grande variedade de recursos educativos centrados no negócio da liga e noutras áreas da indústria desportiva. Cada programa tem um plano de estudos único e conta com oradores convidados excepcionais: profissionais com um passado desportivo distinto que oferecem os seus conhecimentos sobre os temas mais relevantes.
A TECH foi reconhecida pela NBA, a liga de basquetebol mais importante do mundo, como a sua universidade online oficial.
A universidade mais bem classificada pelos seus alunos
A Global score posicionou a TECH como a universidade mais bem avaliada do mundo pelos seus estudantes. Este portal de avaliação, o mais fiável e prestigiado porque verifica e valida a autenticidade de cada opinião publicada, atribuiu à TECH a sua classificação mais elevada, 4,9 em 5, com base em mais de 1000 avaliações recebidas. Estes números colocam a TECH como a referência universitária internacional absoluta. Estes resultados consolidam a TECH como uma instituição universitária de referência internacional, refletindo a excelência e o impacto positivo do seu modelo educativo”
A TECH é a universidade mais bem classificada pelos seus alunos no mundo.
Líderes em empregabilidade
A TECH conseguiu tornar-se a universidade líder em empregabilidade. 99% dos seus estudantes conseguem um emprego na área académica que estudaram, no prazo de um ano após a conclusão de qualquer um dos programas da universidade. Um número semelhante consegue uma melhoria imediata da sua carreira. Tudo isto graças a uma metodologia de estudo que baseia a sua eficácia na aquisição de competências práticas, absolutamente necessárias para o desenvolvimento profissional.
99% dos alunos da TECH conseguem emprego em menos de um ano após a conclusão dos seus estudos.
.